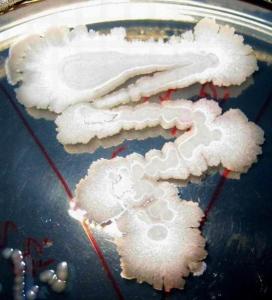
芽孢八叠球菌属

八叠球菌形态

八叠球菌
图片尺寸420x427
八叠球菌
图片尺寸450x370
减肥术后的新威胁:八叠球菌
图片尺寸640x478
第一章原核生物的形态,构造和功能ppt
图片尺寸1080x810
01 morphology and struction of bacteriappt tetrad(四连球菌)
图片尺寸1080x810
2p1细菌的形态结构观察实验p2革兰染色实验p3消毒灭菌实验#红蓝铅笔
图片尺寸1080x998
环境微生物学第一周1ppt
图片尺寸1080x810
芽孢八叠球菌属
图片尺寸272x300
2细菌的形态与结构ppt
图片尺寸1080x810
球形野生菌 这是什么野生菌,球形,很有弹性,完全展开后为鲜红色.
图片尺寸600x802
细菌形态与大小球菌,分为单球菌,双球菌,链球菌,四链球菌,八叠球菌
图片尺寸1680x1904
一般细菌涂片找到g球菌和g杆菌_挂云帆
图片尺寸361x371
01-1 细菌的形态结构与分类 微生物与免疫学ppt
图片尺寸1080x810
介绍微生物类群及形态结构 1, 球 菌 (4)八叠球菌 按三个互相垂直的平
图片尺寸1080x810
【第二十八讲】天下谁人不识"君"_球菌
图片尺寸913x880
①球菌:球菌是一类菌体呈球形或近似球形的细菌.
图片尺寸827x412
球菌
图片尺寸220x151
八叠球菌
图片尺寸1080x810
细菌的形态和染色 单球菌 双球菌 链球菌 四联球菌 八叠球菌 葡萄球菌
图片尺寸1080x810
细菌的基本形态观察 球菌 (葡萄球菌)
图片尺寸1080x810